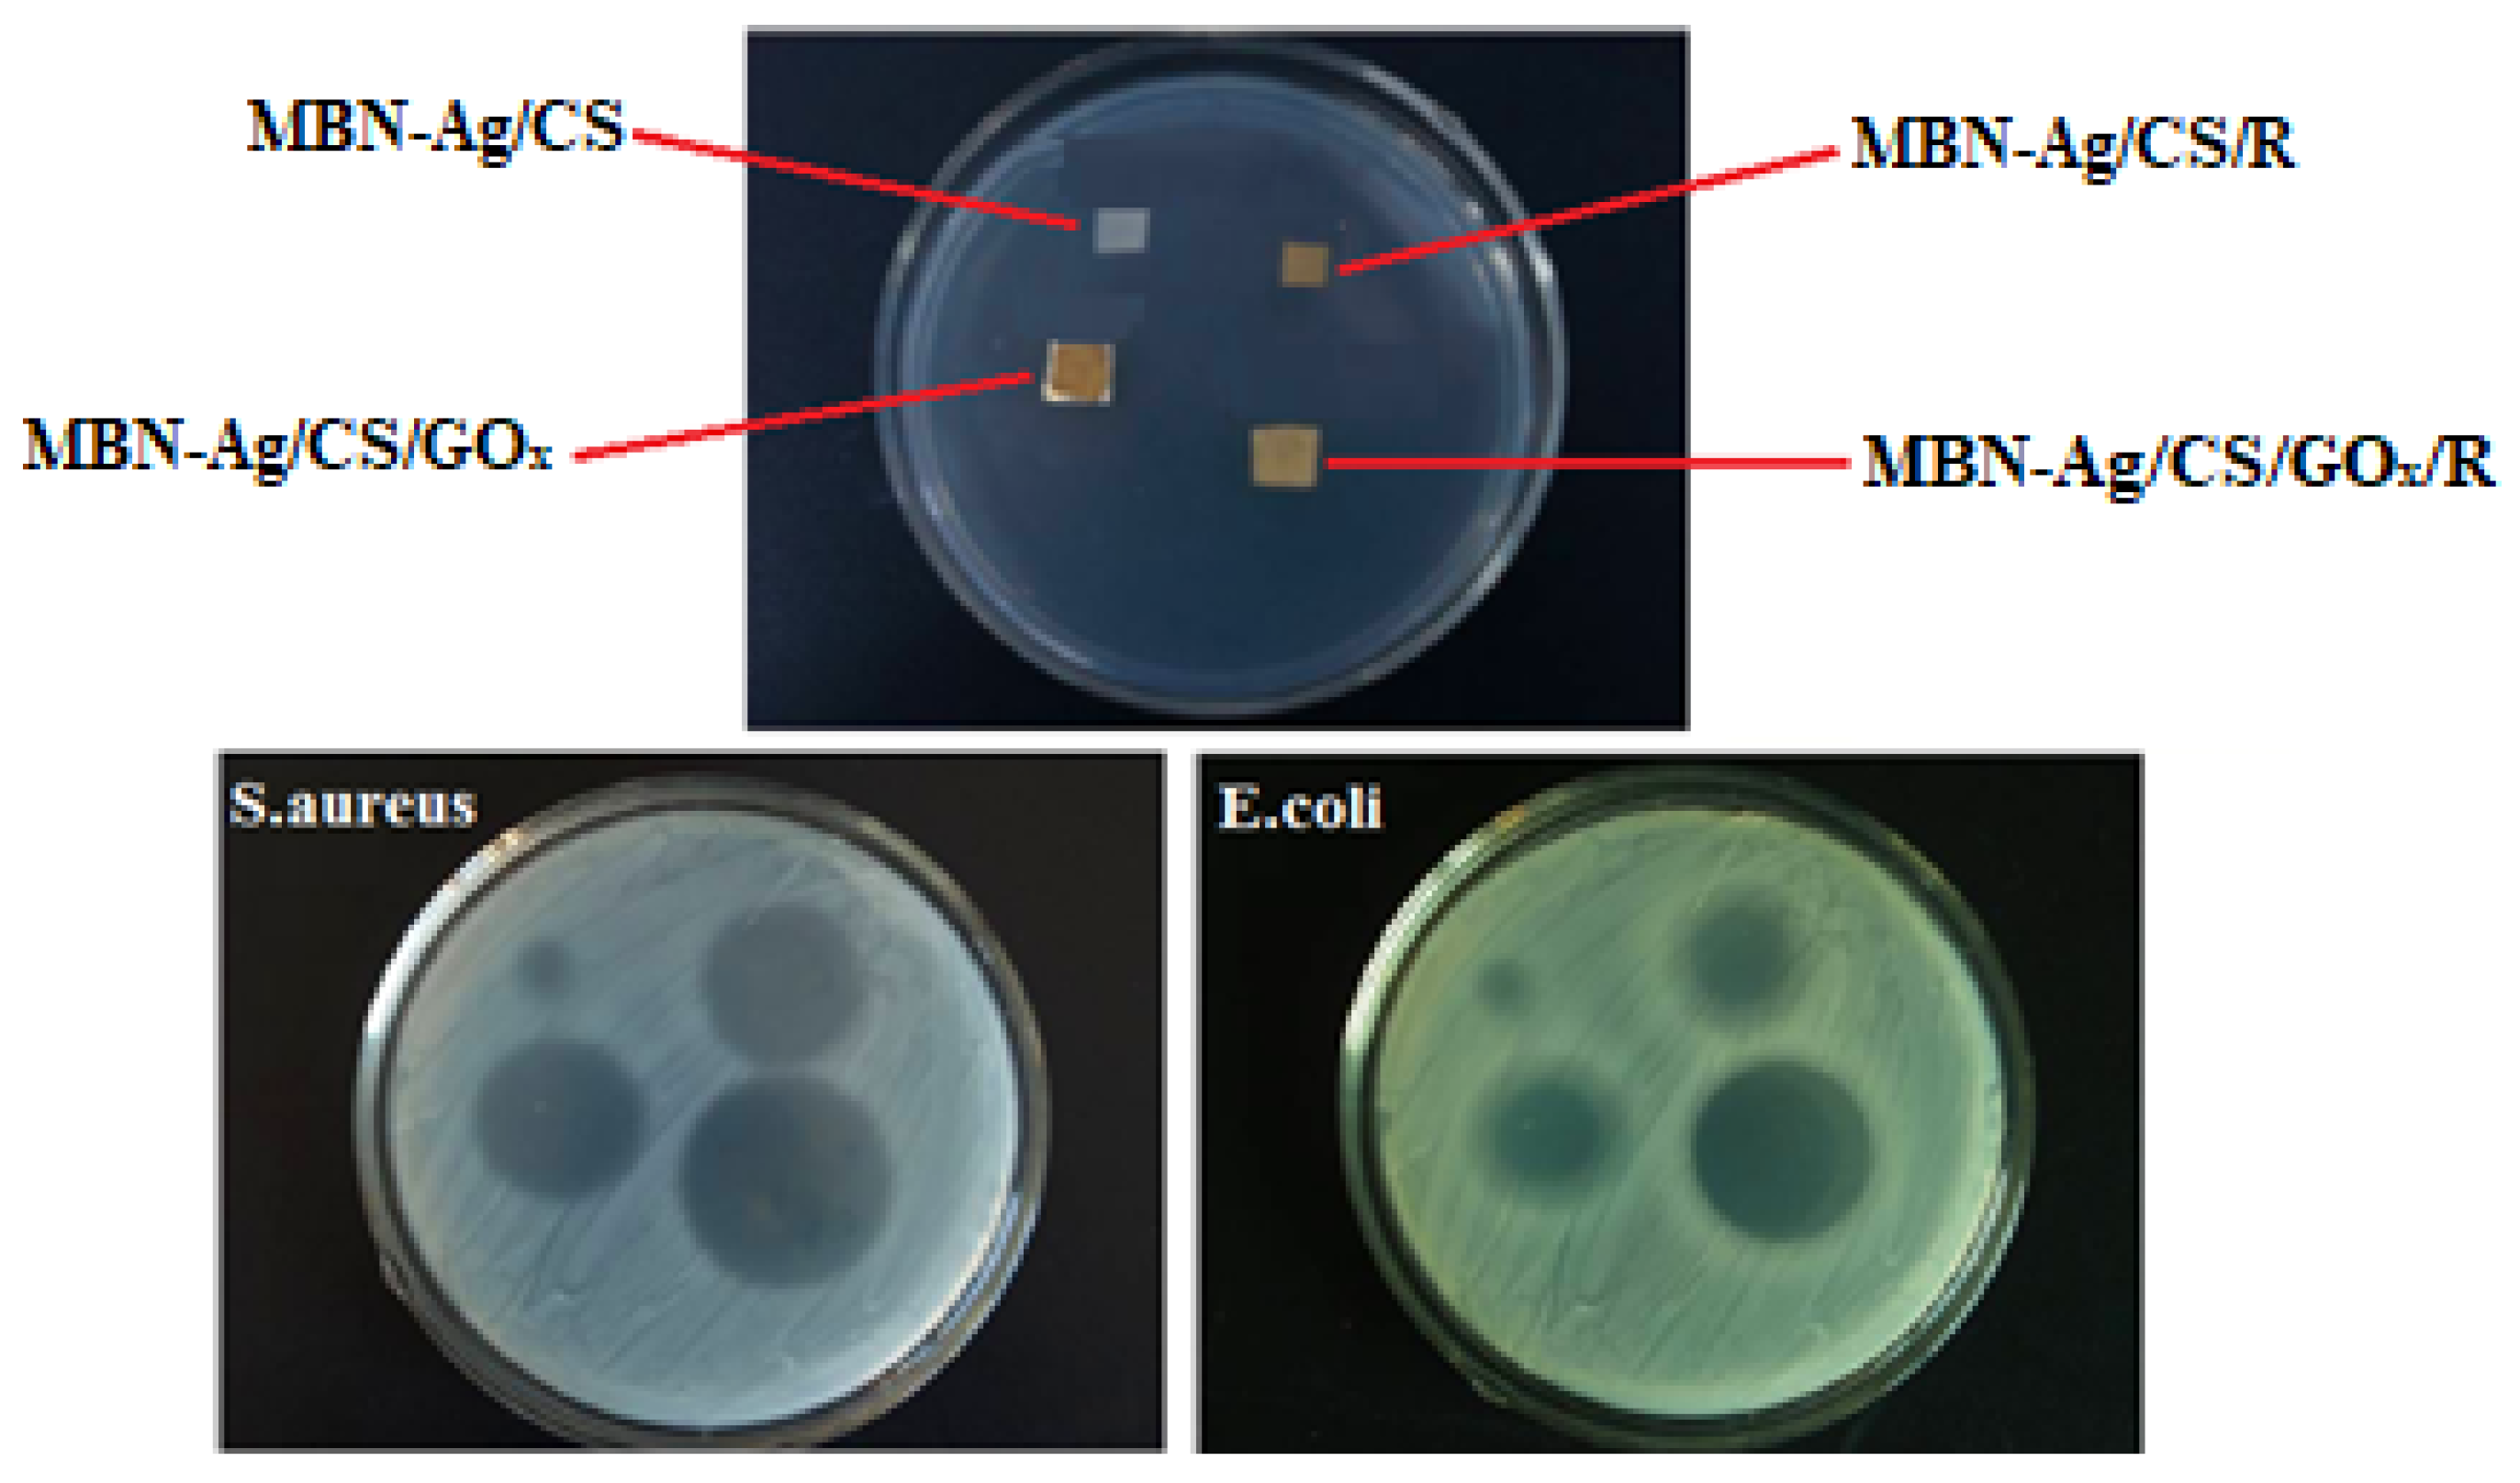
Coatings 14 00411 g013

Novel Polyamide/Chitosan Nanofibers Containing Glucose Oxidase and Rosemary Extract: Fabrication and Antimicrobial Functionality
Abstract
1. Introduction
- Maintaining a high surface area for enzymes or bioactive components for bonding [26];
- Providing a high mass transfer rate, from an electrospun substrate to the active sites of an enzyme;
- Representing a highly durable performance for multiple usages;
2. Materials and Methods
2.1. Materials
2.2. Extraction
2.3. Fabrication of MBN-Ag/CS Nanofibers Containing RO and GOx
2.4. Design of Experiments
2.5. Chemical Analysis by FTIR Spectroscopy
2.6. Morphological Analysis by FESEM
2.7. Antibacterial Test
2.8. The Glucose Oxidase Activity Determination
2.9. Food Packaging Experiments
3. Results and Discussion
3.1. Identifying the Impact of Variables on Preservation (%) Values
3.2. The Morphology of Nanofibers
3.3. The Inhibitory Effect of Silver on Glucose Oxidase
3.4. Antibacterial Studies
3.5. FTIR Analysis
3.6. Application of Electrospun Nanofibers in Food Packaging
4. Conclusions
Author Contributions
Funding
Institutional Review Board Statement
Informed Consent Statement
Data Availability Statement
Conflicts of Interest
References
- Wu, X.; Liu, Z.; He, S.; Liu, J.; Shao, W. Development of an edible food packaging gelatin/zein based nanofiber film for the shelf-life extension of strawberries. Food Chem. 2023, 426, 136652. [Google Scholar] [CrossRef] [PubMed]
- Robertson, G.L. Food Packaging. In Encyclopedia of Agriculture and Food Systems; Van Alfen, N.K., Ed.; Academic Press: Oxford, UK, 2014; pp. 232–249. [Google Scholar]
- Robertson, G.L. Food Packaging: Princible and Practice, 2nd ed.; Routledge: London, UK, 2006. [Google Scholar]
- Muthu Kumar, T.S.; Senthil Kumar, K.; Rajini, N.; Siengchin, S.; Ayrilmis, N.; Varada Rajulu, A. A Comprehensive Review of Electrospun Nanofibers: Food and Packaging Perspective. Compos. Part B Eng. 2019, 175, 107074. [Google Scholar] [CrossRef]
- Ansarifar, E.; Moradinezhad, F. Encapsulation of thyme essential oil using electrospun zein fiber for strawberry preservation. Chem. Biol. Technol. Agric. 2022, 9, 2. [Google Scholar] [CrossRef]
- Wang, F.; Xie, C.; Tang, H.; Hao, W.; Wu, J.; Sun, Y.; Sun, J.; Liu, Y.; Jiang, L. Development, characterization and application of intelligent/active packaging of chitosan/chitin nanofibers films containing eggplant anthocyanins. Food Hydrocoll. 2023, 139, 108496. [Google Scholar] [CrossRef]
- Yildirim, S.; Röcker, B.; Pettersen, M.K.; Nilsen-Nygaard, J.; Ayhan, Z.; Rutkaite, R.; Radusin, T.; Suminska, P.; Marcos, B.; Coma, V. Active Packaging Applications for Food. Compr. Rev. Food Sci. Food Saf. 2018, 17, 165. [Google Scholar] [CrossRef]
- Zhong, T.; Oporto, G.S.; Jaczynski, J. 19—Antimicrobial Food Packaging with Cellulose-Copper Nanoparticles Embedded in Thermoplastic Resins. In Food Preservation; Grumezescu, A.M., Ed.; Academic Press: Cambridge, MA, USA, 2017; pp. 671–702. [Google Scholar]
- Dilbraiz, M.A.; Ahmed, N.; Javid, M.T.; Zada, A.; Wazir, H.U.; Ahmed, S. Varied Morphological Study of Albite Nanomaterials at Low Temperature with Co-effect of Single Walled Nanotubes and Graphene Oxide for Kevlar Fabric Strength. Mater. Innov. 2022, 2, 1–14. [Google Scholar] [CrossRef]
- MohammadAzmin, S.N.H.; Hayat, N.A.B.M.; Nor, M.S.M. Development and Characterization of Food Packaging Bioplastic Film From Cocoa Pod Husk Cellulose Incorporated With Sugarcane Bagasse Fibre. J. Bioresour. Bioprod. 2020, 5, 248–255. [Google Scholar]
- Cherpinski, A.; Gozutok, M.; Sasmazel, H.T.; Torres-Giner, S.; Lagaron, J.M. Electrospun Oxygen Scavenging Films of Poly(3-Hydroxybutyrate) Containing Palladium Nanoparticles for Active Packaging Applications. Nanomaterials 2018, 8, 469. [Google Scholar] [CrossRef] [PubMed]
- Zhang, Y.; Min, T.; Zhao, Y.; Cheng, C.; Yin, H.; Yue, J. The developments and trends of electrospinning active food packaging: A review and bibliometrics analysis. Food Control. 2024, 160, 110291. [Google Scholar] [CrossRef]
- Panda, P.K.; Park, K.; Seo, J. Development of poly (vinyl alcohol)/regenerated chitosan blend film with superior barrier, antioxidant, and antibacterial properties. Prog. Org. Coat. 2023, 183, 107749. [Google Scholar] [CrossRef]
- Barbiroli, A.; Bonomi, F.; Capretti, G.; Iametti, S.; Manzoni, M.; Piergiovanni, L.; Rollini, M. Antimicrobial Activity of Lysozyme and Lactoferrin Incorporated in Cellulose-Based Food Packaging. Food Control. 2012, 26, 387. [Google Scholar] [CrossRef]
- Lian, Z.X.; Ma, Z.S.; Wei, J.; Liu, H. Preparation and Characterization of Immobilized Lysozyme and Evaluation of Its Application in Edible Coatings. Process Biochem. 2012, 47, 201. [Google Scholar] [CrossRef]
- Ge, L.; Zhao, Y.S.; Mo, T.; Li, J.R.; Li, P. Immobilization of Glucose Oxidase in Electrospun Nanofibrous Membranes for Food Preservation. Food Control. 2012, 26, 188. [Google Scholar] [CrossRef]
- Bai, R.; Shao, H.; Chang, H.; Wang, H.; Ding, X.; Cao, W.; Cao, Y.; Lin, T. Novel piezoelectric properties of electrospun polyamide-imide nanofiber membranes. J. Mater. Chem. A 2023, 11, 26230. [Google Scholar] [CrossRef]
- Cowan, D.A.; Fernandez-Lafuente, R. Enhancing the Functional Properties of Thermophilic Enzymes by Chemical Modification and Immobilization. Enzym. Microb. Technol. 2011, 49, 326. [Google Scholar] [CrossRef] [PubMed]
- Rebroš, M.; Rosenberg, M.; Mlichova, Z.; Krištofíková, Ľ. Hydrolysis of Sucrose by Invertase Entrapped in Polyvinyl Alcohol Hydrogel Capsules. Food Chem. 2007, 102, 784. [Google Scholar] [CrossRef]
- Naidu, A.S. Natural Food Antimicrobial Systems; CRC Press: Boca Raton, FL, USA, 2000. [Google Scholar]
- Khatami, S.H.; Vakili, O.; Ahmadi, N.; Fard, E.S.; Mousavi, P.; Khalvati, B.; Maleksabet, A.; Savardashtaki, A.; Taheri-Anganeh, M.; Movahedpour, A. Application of Biopreservatives in Meat Preservation: A Review. Biotechnol. Appl. Biochem. 2021. ahead of print. [Google Scholar]
- Bucekova, M.; Jardekova, L.; Juricova, V.; Bugarova, V.; Di Marco, G.; Gismondi, A.; Leonardi, D.; Farkasovska, J.; Godocikova, J.; Laho, M.; et al. Antibacterial Activity of Different Blossom Honeys: New Findings. J. Mol. 2019, 24, 1573. [Google Scholar] [CrossRef] [PubMed]
- Jjagwe, J.; Olupot, P.W.; Menya, E.; Kalibbala, H.M. Synthesis and Application of Granular Activated Carbon from Biomass Waste Materials for Water Treatment: A Review. J. Bioresour. Bioprod. 2021, 6, 292–322. [Google Scholar] [CrossRef]
- Fernández, A.; Cava, D.; Ocio, M.J.; Lagarón, J.M. Perspectives for Biocatalysts in Food Packaging. Trends Food Sci. Technol. 2008, 19, 198. [Google Scholar] [CrossRef]
- Lopez-Rubio, A.; Gavara, R.; Lagaron, J.M. Bioactive Packaging: Turning Foods into Healthier Foods Through Biomaterials. Trends Food Sci. Technol. 2006, 17, 567. [Google Scholar] [CrossRef]
- Ognibene, G.; Cristaldi, D.A.; Fiorenza, R.; Blanco, I.; Cicala, G.; Scirè, S.; Fragalà, M.E. Photoactivity of Hierarchically Nanostructured Zno–PES Fibre Mats for Water Treatments. RSC Adv. 2016, 6, 42778–42785. [Google Scholar] [CrossRef]
- Ren, G.; Xu, X.; Liu, Q.; Cheng, J.; Yuan, X.; Wu, L.; Wan, Y. Electrospun Poly (Vinyl Alcohol)/Glucose Oxidase Biocomposite Membranes for Biosensor Applications. React. Funct. Polym. 2006, 66, 1559. [Google Scholar] [CrossRef]
- Hu, Y.; Jia, J.; Qiao, J.; Ge, C.; Cao, Z. Antimicrobial Activity of Pu-Erh Tea Extracts in Vitro and Its Effects on the Preservation of Cooled Mutton. J. Food Saf. 2010, 30, 177. [Google Scholar] [CrossRef]
- Song, D.-H.; Hoa, V.B.; Kim, H.W.; Khang, S.M.; Cho, S.-H.; Ham, J.-S.; Seol, K.-H. Edible Films on Meat and Meat Products. Coatings 2021, 11, 1344. [Google Scholar] [CrossRef]
- Magovac, E.; Vončina, B.; Budimir, A.; Jordanov, I.; Grunlan, J.C.; Bischof, S. Environmentally Benign Phytic Acid-Based Nanocoating for Multifunctional Flame-Retardant/Antibacterial Cotton. Fibers 2021, 9, 69. [Google Scholar] [CrossRef]
- Bonilla, J.; Sobral, P.J.D.A. Antioxidant and Antimicrobial Properties of Ethanolic Extracts of Guarana, Boldo, Rosemary and Cinnamon. Braz. J. Food Technol. 2017, 20. [Google Scholar] [CrossRef]
- López de Dicastillo, C.; Garrido, L.; Alvarado, N.; Romero, J.; Palma, J.L.; Galotto, M.J. Improvement of Polylactide Properties Through Cellulose Nanocrystals Embedded in Poly(Vinyl Alcohol) Electrospun Nanofibers. Nanomaterials 2017, 7, 106. [Google Scholar] [CrossRef] [PubMed]
- Zaharescu, T.; Blanco, I. Stabilization Effects of Natural Compounds and Polyhedral Oligomeric Silsesquioxane Nanoparticles on the Accelerated Degradation of Ethylene-Propylene-Diene Monomer. Molecules 2021, 26, 4390. [Google Scholar] [CrossRef] [PubMed]
- Gómez-Estaca, J.; Bravo, L.; Gómez-Guillén, M.; Alemán, A.; Montero, P. Antioxidant Properties of Tuna-Skin and Bovine-Hide Gelatin Films Induced by the Addition of Oregano and Rosemary Extracts. Food Chem. 2009, 112, 18–25. [Google Scholar] [CrossRef]
- Farghal, H.H.; Karabagias, I.; El Sayed, M.; Kontominas, M.G. Determination of Antioxidant Activity of Surface-Treated PET Films Coated with Rosemary and Clove Extracts. Packag. Technol. Sci. 2017, 30, 799–808. [Google Scholar] [CrossRef]
- Kakoria, A.; Sinha-Ray, S. A Review on Biopolymer-Based Fibers via Electrospinning and Solution Blowing and Their Applications. Fibers 2018, 6, 45. [Google Scholar] [CrossRef]
- Valerini, D.; Tammaro, L.; Vitali, R.; Rinaldi, A. Sputter-Deposited Ag Nanoparticles on Electrospun Pcl Scaffolds: Morphology, Wettability and Antibacterial Activity. Coatings 2021, 11, 345. [Google Scholar] [CrossRef]
- Manilal, A.; Sabu, K.R.; Woldemariam, M.; Aklilu, A.; Biresaw, G.; Yohanes, T.; Seid, M.; Merdekios, B. Antibacterial Activity of Rosmarinus officinalis against Multidrug-Resistant Clinical Isolates and Meat-Borne Pathogens. Hindawi Evid. Based Complement. Altern. Med. 2021, 2021, 6677420. [Google Scholar] [CrossRef] [PubMed]
- Dobbenie, D.; Uyttendaele, M.; Debevere, J. Antibacterial Activity of the Glucose Oxidase/Glucose System in Liquid Whole Egg. J. Food Prot. 1995, 58, 273–279. [Google Scholar] [CrossRef] [PubMed]
- Keirouz, A.; Radacsi, N.; Ren, Q.; Dommann, A.; Beldi, G.; Maniura-Weber, K.; Rossi, R.M.; Fortunato, G. Nylon-6/chitosan core/shell antimicrobial nanofibers for the prevention of mesh-associated surgical site infection. J. Nanobiotechnol. 2020, 18, 51. [Google Scholar] [CrossRef] [PubMed]
- Xu, Z.; Mahalingam, S.; Rohn, J.L.; Ren, G.; Edirisinghe, M. Physio-chemical and antibacterial characteristics of pressure spun nylon nanofibres embedded with functional silver nanoparticles. Mater. Sci. Eng. C 2015, 56, 195–204. [Google Scholar] [CrossRef] [PubMed]
- Zhang, H.; Li, S.; Whit, C.J.B.; Ning, X.; Nie, H.; Zhu, L. Studies on Electrospun Nylon-6/Chitosan Complex Nanofiber Interactions. Electrochim. Acta 2009, 54, 5739. [Google Scholar] [CrossRef]
- Al-Deyab, S.S.; El-Newehy, M.H.; Nirmala, R.; Abdel-Megeed, A.; Kim, H.Y. Antimicrobial Surfaces for Craniofacial Implants: State of the Art. Korean J. Chem. Eng. 2013, 30, 422. [Google Scholar] [CrossRef]
- Jia, Y.T.; Gong, J.; Gu, X.H.; Kim, H.Y.; Dong, J.; Shen, X.Y. Fabrication and Characterization of Poly (Vinyl Alcohol)/Chitosan Blend Nanofibers Produced by Electrospinning Method. Carbohydr. Polym. 2007, 67, 403. [Google Scholar] [CrossRef]
- Ramakrishna, S.; Fujihara, K.; Teo, W.E.; Lim, T.C.; Ma, Z. Basics Relevant to Electrospinning; World Scientific Publishing Co., Pte. Ltd.: Singapore, 2005. [Google Scholar]
- Tan, S.-H.; Inai, R.; Kotaki, M.; Ramakrishna, S. Systematic Parameter Study for Ultra-Fine Fiber Fabrication via Electrospinning Process. Polymer 2005, 46, 6128–6134. [Google Scholar] [CrossRef]
- Leonarta, F.; Lee, C.-K. Nanofibrous Membrane with Encapsulated Glucose Oxidase for Self-Sustained Antimicrobial Applications. Membranes. 2021, 11, 997. [Google Scholar] [CrossRef] [PubMed]
- Andrady, A.L. Science and Technology of Polymer Nanofibers; John Wiley&Sons: Hoboken, NJ, USA, 2008. [Google Scholar]
- Megelski, S.; Stephens, J.S.; Chase, D.B.; Rabolt, J.F. Micro- and Nanostructured Surface Morphology on Electrospun Polymer Fibers. Macromolecules 2002, 35, 8456–8466. [Google Scholar] [CrossRef]
- Jiang, Y.; Wu, N.; Fu, Y.-J.; Wang, W.; Luo, M.; Zhao, C.-J.; Zu, Y.-G.; Liu, X.-L. Chemical Composition and Antimicrobial Activity of The Essential Oil of Rosemary. Environ. Toxicol. Pharmacol. 2011, 32, 63–68. [Google Scholar] [CrossRef] [PubMed]
- Nieto, G.; Ros, G.; Castillo, J. Antioxidant and Antimicrobial Properties of Rosemary (Rosmarinus officinalis, L.): A Review. Medicines 2018, 5, 98. [Google Scholar] [CrossRef] [PubMed]
- Noralian, Z.; Gashti, M.P.; Moghaddam, M.R.; Tayyeb, H.; Erfanian, I. Ultrasonically Developed Silver/Iota-Carrageenan/Cotton Bionanocomposite as an Efficient Material for Biomedical Applications. Int. J. Biol. Macromol. 2021, 180, 439. [Google Scholar] [CrossRef] [PubMed]
- Gashti, M.P.; Dehghan, N. Gel Diffusion-Inspired Biomimetic Calcium Iodate/Gelatin Composite Particles: Structural Characterization and Antibacterial Activity. J. Solid State Chem. 2020, 285, 121262. [Google Scholar] [CrossRef]
- Topuz, F.; Uyar, T. Antioxidant, antibacterial and antifungal electrospun nanofibers for food packaging applications. Food Res. Int. 2020, 130, 108927. [Google Scholar] [CrossRef] [PubMed]
- Elashnikov, R.; Rimpelová, S.; Vosmanská, V.; Kolská, Z.; Kolářová, K.; Lyutakov, O.; Švorčík, V. Effect of sterilization methods on electrospun cellulose acetate butyrate nanofibers for SH-SY5Y cultivation. React. Funct. Polym. 2019, 143, 104339. [Google Scholar] [CrossRef]
- Romano, C.S.; Abadi, K.; Repetto, V.; Vojnov, A.A.; Moreno, S. Synergistic Antioxidant and Antibacterial Activity of Rosemary Plus Butylated Derivatives. Food Chem. 2009, 115, 456. [Google Scholar] [CrossRef]
- Klančnik, A.; Piskernik, S.; Jeršek, B.; Možina, S.S. Evaluation of Diffusion and Dilution Methods to Determine the Antibacterial Activity of Plant Extracts. J. Microbiol. Methods 2010, 81, 121–126. [Google Scholar] [CrossRef] [PubMed]
- Gashti, M.P.; Shokri, A. Hydrogel-Assisted Low-Temperature Synthesis of Calcium Borate Nanoparticles. J. Aust. Ceram. Soc. 2018, 54, 601–607. [Google Scholar] [CrossRef]
- Gashti, M.P.; Helali, M.; Karimi, S. Biomineralization-Inspired Green Synthesis of Zinc Phosphate-Based Nanosheets in Gelatin Hydrogel. Int. J. Appl. Ceram. Technol. 2016, 13, 1069–1073. [Google Scholar] [CrossRef]
- Gashti, M.P.; Burgener, M.; Stir, M.; Hulliger, J. Barium Hydrogen Phosphate/Gelatin Composites Versus Gelatin-Free Barium Hydrogen Phosphate: Synthesis and Characterization of Properties. J. Colloid Interface Sci. 2014, 431, 149–156. [Google Scholar] [CrossRef]
- Gashti, M.P.; Hegemann, D.; Stir, M.; Hulliger, J. Thin Film Plasma Functionalization of Polyethylene Terephthalate to Induce Bone-Like Hydroxyapatite Nanocrystals. Plasma Process. Polym. 2013, 11, 37–43. [Google Scholar] [CrossRef]
- Hong, W.; Li, Q.S.; Jiao, J.; Guo, H.L.; Sun, J.; Liu, J.; Guo, B.; Xing, G.Z. Research on the Preparation of Food-grade Sea Cucumber/Gelatin Nanofiber Membrane with Electrospinning Method. Adv. Mater. Res. 2012, 427, 139–142. [Google Scholar] [CrossRef]

| Run | MBN-Ag (wt%) | CS (%) | MBN-Ag/CS (Ratios of wt%) | RO (%) | GOx (g) | Preservation (%) |
|---|---|---|---|---|---|---|
| 1 | 7 | 1 | 30 | 1.25 | 0.04 | 91 |
| 2 | 6 | 1 | 50 | 1.25 | 0.04 | 72 |
| 3 | 7 | 3 | 70 | 1.25 | 0.04 | 0 |
| 4 | 8 | 1 | 50 | 1.25 | 0.04 | 60 |
| 5 | 6 | 3 | 50 | 1.25 | 0.04 | 63 |
| 6 | 7 | 2 | 30 | 1.25 | 0.07 | 90 |
| 7 | 7 | 1 | 50 | 0.5 | 0.04 | 20 |
| 8 | 6 | 2 | 50 | 0.5 | 0.04 | 38 |
| 9 | 7 | 2 | 50 | 1.25 | 0.04 | 80 |
| 10 | 7 | 2 | 30 | 2 | 0.04 | 85 |
| 11 | 7 | 2 | 70 | 1.25 | 0.07 | 0 |
| 12 | 7 | 1 | 50 | 2 | 0.04 | 50 |
| 13 | 6 | 2 | 50 | 1.25 | 0.01 | 29 |
| 14 | 7 | 3 | 50 | 0.5 | 0.04 | 45 |
| 15 | 6 | 2 | 30 | 1.25 | 0.04 | 78 |
| 16 | 7 | 2 | 70 | 1.25 | 0.01 | 0 |
| 17 | 7 | 2 | 50 | 1.25 | 0.04 | 80 |
| 18 | 7 | 3 | 50 | 2 | 0.04 | 65 |
| 19 | 7 | 2 | 50 | 1.25 | 0.04 | 80 |
| 20 | 7 | 3 | 30 | 1.25 | 0.04 | 88 |
| 21 | 7 | 2 | 50 | 1.25 | 0.04 | 80 |
| 22 | 7 | 2 | 30 | 1.25 | 0.01 | 91 |
| 23 | 7 | 3 | 50 | 1.25 | 0.07 | 56 |
| 24 | 8 | 2 | 50 | 2 | 0.04 | 85 |
| 25 | 7 | 1 | 70 | 1.25 | 0.04 | 0 |
| 26 | 8 | 2 | 30 | 1.5 | 0.05 | 95 |
| 27 | 8 | 2 | 50 | 1.25 | 0.07 | 70 |
| 28 | 7 | 2 | 50 | 2 | 0.07 | 57 |
| 29 | 6 | 2 | 70 | 1.25 | 0.04 | 0 |
| 30 | 7 | 2 | 50 | 2 | 0.01 | 63 |
| 31 | 8 | 3 | 50 | 1.25 | 0.04 | 40 |
| 32 | 7 | 1 | 50 | 1.25 | 0.07 | 47 |
| 33 | 6 | 2 | 50 | 1.25 | 0.07 | 67 |
| 34 | 7 | 2 | 50 | 1.25 | 0.04 | 80 |
| 35 | 8 | 2 | 70 | 1.25 | 0.04 | 0 |
| 36 | 7 | 2 | 50 | 1.25 | 0.04 | 80 |
| 37 | 7 | 1 | 50 | 1.25 | 0.01 | 38 |
| 38 | 7 | 2 | 30 | 0.5 | 0.04 | 42 |
| 39 | 7 | 2 | 70 | 2 | 0.04 | 0 |
| 40 | 8 | 2 | 50 | 1.25 | 0.01 | 25 |
| 41 | 7 | 2 | 50 | 0.5 | 0.07 | 38 |
| 42 | 8 | 2 | 50 | 0.5 | 0.04 | 25 |
| 43 | 7 | 3 | 50 | 1.25 | 0.01 | 66 |
| 44 | 7 | 2 | 70 | 0.5 | 0.04 | 0 |
| 45 | 7 | 2 | 50 | 0.5 | 0.01 | 59 |
| 46 | 6 | 2 | 50 | 2 | 0.04 | 58 |
| Source | Sum of Squares | df | Mean Square | F-Value | p-Value | |
|---|---|---|---|---|---|---|
| Model | 38,039.71 | 20 | 1901.99 | 10.70 | <0.0001 | significant |
| A (MBN-Ag) | 13.57 | 1 | 13.57 | 0.0764 | 0.7846 | |
| B (CS) | 126.56 | 1 | 126.56 | 0.7122 | 0.4067 | |
| C (MBN-Ag/CS) | 26,218.88 | 1 | 26,218.88 | 147.54 | <0.0001 | |
| D (RO) | 2424.03 | 1 | 2424.03 | 13.64 | 0.0011 | |
| E (GOx) | 187.03 | 1 | 187.03 | 1.05 | 0.3148 | |
| AB | 30.25 | 1 | 30.25 | 0.1702 | 0.6834 | |
| AC | 12.59 | 1 | 12.59 | 0.0709 | 0.7923 | |
| AD | 417.86 | 1 | 417.86 | 2.35 | 0.1377 | |
| AE | 14.69 | 1 | 14.69 | 0.0826 | 0.7761 | |
| BC | 2.25 | 1 | 2.25 | 0.0127 | 0.9113 | |
| BD | 25.00 | 1 | 25.00 | 0.1407 | 0.7108 | |
| BE | 90.25 | 1 | 90.25 | 0.5079 | 0.4827 | |
| CD | 481.88 | 1 | 481.88 | 2.71 | 0.1121 | |
| CE | 0.0378 | 1 | 0.0378 | 0.0002 | 0.9885 | |
| DE | 57.88 | 1 | 57.88 | 0.3257 | 0.5733 | |
| A2 | 1483.10 | 1 | 1483.10 | 8.35 | 0.0079 | |
| B2 | 1367.26 | 1 | 1367.26 | 7.69 | 0.0103 | |
| C2 | 5514.96 | 1 | 5514.96 | 31.03 | <0.0001 | |
| D2 | 2950.68 | 1 | 2950.68 | 16.60 | 0.0004 | |
| E2 | 1452.53 | 1 | 1452.53 | 8.17 | 0.0085 | |
| Residual | 4442.73 | 25 | 177.71 | |||
| Lack of Fit | 4442.73 | 20 | 222.14 | |||
| Pure Error | 0.0000 | 5 | 0.0000 | |||
| Cor Total | 42,482.43 | 45 |
Disclaimer/Publisher’s Note: The statements, opinions and data contained in all publications are solely those of the individual author(s) and contributor(s) and not of MDPI and/or the editor(s). MDPI and/or the editor(s) disclaim responsibility for any injury to people or property resulting from any ideas, methods, instructions or products referred to in the content. |
© 2024 by the authors. Licensee MDPI, Basel, Switzerland. This article is an open access article distributed under the terms and conditions of the Creative Commons Attribution (CC BY) license (https://creativecommons.org/licenses/by/4.0/).
Share and Cite
Fard, G.C.; Parvinzadeh Gashti, M.; Dehdast, S.A.; Shabani, M.; Zarinabadi, E.; Seifi, N.; Berenjian, A. Novel Polyamide/Chitosan Nanofibers Containing Glucose Oxidase and Rosemary Extract: Fabrication and Antimicrobial Functionality. Coatings 2024, 14, 411. https://doi.org/10.3390/coatings14040411
Fard GC, Parvinzadeh Gashti M, Dehdast SA, Shabani M, Zarinabadi E, Seifi N, Berenjian A. Novel Polyamide/Chitosan Nanofibers Containing Glucose Oxidase and Rosemary Extract: Fabrication and Antimicrobial Functionality. Coatings. 2024; 14(4):411. https://doi.org/10.3390/coatings14040411
Chicago/Turabian StyleFard, Ghazaleh Chizari, Mazeyar Parvinzadeh Gashti, Seyed Ahmad Dehdast, Mohammad Shabani, Ehsan Zarinabadi, Negin Seifi, and Ali Berenjian. 2024. "Novel Polyamide/Chitosan Nanofibers Containing Glucose Oxidase and Rosemary Extract: Fabrication and Antimicrobial Functionality" Coatings 14, no. 4: 411. https://doi.org/10.3390/coatings14040411
APA StyleFard, G. C., Parvinzadeh Gashti, M., Dehdast, S. A., Shabani, M., Zarinabadi, E., Seifi, N., & Berenjian, A. (2024). Novel Polyamide/Chitosan Nanofibers Containing Glucose Oxidase and Rosemary Extract: Fabrication and Antimicrobial Functionality. Coatings, 14(4), 411. https://doi.org/10.3390/coatings14040411

